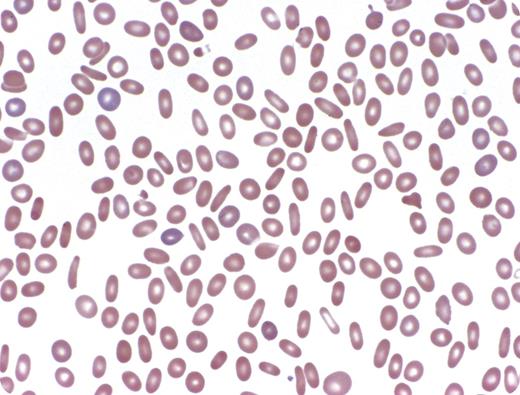
A 75-year-old man with a 5-year history of myelodysplastic syndrome (MDS) subsequently developed worsening fatigue, dizziness, and dyspnea on exertion. There was no family history of hematologic diseases. On examination he was cachectic with no hepatosplenomegaly and petechiae, but purpuric lesions were present on his hands. The complete blood count showed pancytopenia (hemoglobin 10.2 g/dL, white blood cell count 2.8 k/uL, absolute neutrophil count 1.6 k/uL, platelets 23 k/uL) with a mean corpuscular volume of 101.3 fL. Reticulocyte count was not performed. The peripheral smear showed striking elliptocytosis (see figure). Bone marrow biopsy revealed hypercellularity with prominent megakaryocytic and granulocytic dysplastic. Conventional cytogenetic analysis detected a del(20)(q11.2) with a sideline showing a marker chromosome. The earlier hematologic assessment 5 years prior showed an isolated del(20q)(q11.2) with no evidence of elliptocytosis. / Acquired elliptocytosis may be seen in a variety of bone marrow disorders, including architectural disturbances such as fibrosis and myelophthisis. It can also be a manifestation of dysplastic erythropoiesis in the setting of MDS. Acquired elliptocytosis is generally characterized by fewer elliptocytes (< 15% of total red blood cells) than the marked numbers seen in hereditary elliptocytosis (HE). Reports suggest an association between marked elliptocytosis in MDS and del(20q) that was seen in this patient. Diminished production of protein 4.1 (EBP41), a structural RBC protein implicated in some cases of HE, has also been demonstrated in MDS with elliptocytosis. An interesting feature of this case was the acquisition of elliptocytosis as the disease progressed.

A 75-year-old man with a 5-year history of myelodysplastic syndrome (MDS) subsequently developed worsening fatigue, dizziness, and dyspnea on exertion. There was no family history of hematologic diseases. On examination he was cachectic with no hepatosplenomegaly and petechiae, but purpuric lesions were present on his hands. The complete blood count showed pancytopenia (hemoglobin 10.2 g/dL, white blood cell count 2.8 k/uL, absolute neutrophil count 1.6 k/uL, platelets 23 k/uL) with a mean corpuscular volume of 101.3 fL. Reticulocyte count was not performed. The peripheral smear showed striking elliptocytosis (see figure). Bone marrow biopsy revealed hypercellularity with prominent megakaryocytic and granulocytic dysplastic. Conventional cytogenetic analysis detected a del(20)(q11.2) with a sideline showing a marker chromosome. The earlier hematologic assessment 5 years prior showed an isolated del(20q)(q11.2) with no evidence of elliptocytosis.
Acquired elliptocytosis may be seen in a variety of bone marrow disorders, including architectural disturbances such as fibrosis and myelophthisis. It can also be a manifestation of dysplastic erythropoiesis in the setting of MDS. Acquired elliptocytosis is generally characterized by fewer elliptocytes (< 15% of total red blood cells) than the marked numbers seen in hereditary elliptocytosis (HE). Reports suggest an association between marked elliptocytosis in MDS and del(20q) that was seen in this patient. Diminished production of protein 4.1 (EBP41), a structural RBC protein implicated in some cases of HE, has also been demonstrated in MDS with elliptocytosis. An interesting feature of this case was the acquisition of elliptocytosis as the disease progressed.
A 75-year-old man with a 5-year history of myelodysplastic syndrome (MDS) subsequently developed worsening fatigue, dizziness, and dyspnea on exertion. There was no family history of hematologic diseases. On examination he was cachectic with no hepatosplenomegaly and petechiae, but purpuric lesions were present on his hands. The complete blood count showed pancytopenia (hemoglobin 10.2 g/dL, white blood cell count 2.8 k/uL, absolute neutrophil count 1.6 k/uL, platelets 23 k/uL) with a mean corpuscular volume of 101.3 fL. Reticulocyte count was not performed. The peripheral smear showed striking elliptocytosis (see figure). Bone marrow biopsy revealed hypercellularity with prominent megakaryocytic and granulocytic dysplastic. Conventional cytogenetic analysis detected a del(20)(q11.2) with a sideline showing a marker chromosome. The earlier hematologic assessment 5 years prior showed an isolated del(20q)(q11.2) with no evidence of elliptocytosis.
Acquired elliptocytosis may be seen in a variety of bone marrow disorders, including architectural disturbances such as fibrosis and myelophthisis. It can also be a manifestation of dysplastic erythropoiesis in the setting of MDS. Acquired elliptocytosis is generally characterized by fewer elliptocytes (< 15% of total red blood cells) than the marked numbers seen in hereditary elliptocytosis (HE). Reports suggest an association between marked elliptocytosis in MDS and del(20q) that was seen in this patient. Diminished production of protein 4.1 (EBP41), a structural RBC protein implicated in some cases of HE, has also been demonstrated in MDS with elliptocytosis. An interesting feature of this case was the acquisition of elliptocytosis as the disease progressed.
For additional images, visit the ASH IMAGE BANK, a reference and teaching tool that iscontinually updated with new atlas and case study images. For more information visit http://imagebank.hematology.org.

This feature is available to Subscribers Only
Sign In or Create an Account Close Modal